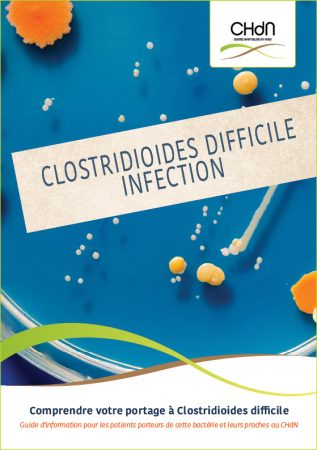

Service de prévention et de contrôle des infections (SPCI)
Notre mission : la sécurité de tous
Le Service de Prévention et de Contrôle des Infections (SPCI) du CHdN a pour mission de garantir la sécurité de nos patients, de nos professionnels de santé et de nos visiteurs en réduisant les risques inhérents aux infections associées aux soins. Grâce à une expertise reconnue et des actions préventives sur l’ensemble des processus du CHdN, nous travaillons quotidiennement à la mise en place des meilleures pratiques cliniques en collaboration de tous les départements de notre centre hospitalier.
Nos objectifs
Le SPCI s’engage à :
- Prévenir les infections associées aux soins (IAS) : en mettant en œuvre des recommandations basées sur des Evidence Based Médecin – Nursing afin de prévenir les IAS et créer de la plus-value pour le patient ainsi que pour l’ensemble de l’écosystème hospitalier.
- Former et sensibiliser : en formant tout le personnel aux mesures de prévention en matière de prévention des IAS et en sensibilisant les patients, les visiteurs, les bénévoles à l’hygiène des mains et aux règles de prévention standard pour le secteur hospitalier.
- Surveiller : en suivant les risques d’infections, en collectant et en analysant des données relatives aux infections dans l’hôpital, en participant également à des programmes de surveillance nationale, européen et en intervenant rapidement en cas d’éclosion d’épidémie.
- Conseiller, accompagner les équipes médico-soignantes et l’ensemble des acteurs de l’hôpital : en les soutenant dans la mise en application des recommandations de bonnes pratiques en prévention et contrôle de l’infection ainsi que dans la gestion des situations à risque pour le patient, pour l’organisation.
Nos missions principales
Les missions du Service Prévention et Contrôle de l’Infection (SPCI) servent à assurer la sécurité des patients, du personnel, des médecins et du public face aux risques infectieux.
Le SPCI joue un rôle clé dans la prévention des infections à travers plusieurs actions :
- Mise en place d’une stratégie de prévention des IAS au niveau du centre hospitalier : piloter, déployer, suivre un programme PCI annuel et en mesurer son efficacité.
- Surveillance épidémiologique : mener des enquêtes épidémiologiques en cas de survenue d’évènements indésirables, participer à des programmes de surveillance des IAS en collaboration des autorités de tutelles, assurer un suivi des IAS dans les différents services, analyser des données et veiller à la mise en place de mesures correctives si nécessaire.
- Surveillance journalière du risque infectieux : déployer des mesures contre la dissémination des bactéries multirésistantes aux antibiotiques et assurer un suivi quotidien des pathogènes et pathologies nécessitant des précautions additionnelles,
- Mise en œuvre de recommandations de bonnes pratiques en matière de Prévention et de contrôle des infections (PCI) : définir les bonnes pratiques professionnelles concourant à la prévention des IAS, élaborer et actualiser les procédures de soins sur le volet « Prévention, contrôle des infections » (PCI), incluant les précautions standard, additionnelles, l’hygiène des mains, la désinfection des surfaces et la gestion des déchets hospitaliers dans une approche d’harmonisation des pratiques professionnelles.
- Gestion des épidémies : intervention rapide en cas d’épidémie ou d’alerte sanitaire, mise en place de plans de prévention et suivi rigoureux des patients et du personnel.
- Formation continue : organisation de sessions régulières de formation à destination du personnel médico-soignant ainsi que le personnel des autres départements sur les bonnes pratiques de prévention des IAS.
- Conseil et expertise : contribuer à l’uniformisation des équipements et produits destinés aux soins en participant au comité institutionnel « achat – investissement ».
- Gestion du risque infectieux lié à l’usage des dispositifs médicaux et à l’environnement hospitalier : surveiller l’environnement hospitalier en termes de risque infectieux (eau, air, eau osmosée, endoscopie etc.) selon la législation en vigueur.
- Partage de compétences et d’expériences : animer un réseau de référents en prévention et contrôle de l’infection (PCI).
- Evaluation des pratiques professionnelles : organisation d’audits réguliers dans l’ensemble des services pour vérifier le respect des recommandations en matière de prévention des IAS et proposer des améliorations si nécessaire dans le cadre d’une démarche d’amélioration continue de notre offre de soin.
Les actions du SPCI sont soutenues activement par notre direction, le Comité de prévention de l’infection nosocomiale (CPIN) et toute la communauté hospitalière du CHdN visant à garantir les meilleures conditions de soins et une sécurité optimale de prise en charge patient.
La prévention des IAS : un engagement à tous les niveaux de notre organisation
Nous croyons fermement que la prévention des infections associées aux soins est une dynamique collective. Nous encourageons tous nos patients, visiteurs et collaborateurs à respecter les mesures d’hygiène simples mais efficaces, comme la désinfection hygiénique des mains au moyen de la solution hydroalcoolique mise à votre disposition à différents endroits clés de l’hôpital.
Comment nous contacter ?
Si vous avez des questions ou des préoccupations concernant la prévention des infections, n’hésitez pas à contacter le SPCI au
8166-5015 ou à nous écrire à hygiene.hospitaliere@chdn.lu. Nous sommes là pour vous accompagner et répondre à toutes vos questions concernant la sécurité et la prévention des infections dans notre hôpital.
Notre équipe
Farid HENACHE, Coordinateur de service SPCI (farid.henache@chdn.lu)
Rudy SURIN, Infirmier hygièniste (rudy.surin@chdn.lu)
Caroline VIDICK, Infirmier hygièniste (caroline.vidick@chdn.lu)
Olivia HODY, Assistante (olivia.hody@chdn.lu)
Dr Styliani BARTZIALI, Médecin hygièniste (styliani.bartziali@chdn.lu)
Brochures d’information
MRSA
Comprendre et prévenir le MRSA. Ce que vous devez savoir pour vous protéger et protéger les autres.
 Téléchargez la version française
Téléchargez la version française
 Téléchargez la version allemande
Téléchargez la version allemande
Clostridioides difficile
Guide d’information pour les patients porteurs de cette bactérie et leurs proches au CHdN
 Téléchargez la version française
Téléchargez la version française
Téléchargez la version allemande
Téléchargez la version allemande
Bactéries multi-résistantes (BMR)
Guide d’information pour les patients porteurs de BMR et leurs proches au CHdN
 Téléchargez la version française
Téléchargez la version française
 Téléchargez la version allemande
Téléchargez la version allemande
Comprendre la Gale (Scabiose)
Guide d’information pour les patients hospitalisés atteints d’une gale au CHdN

